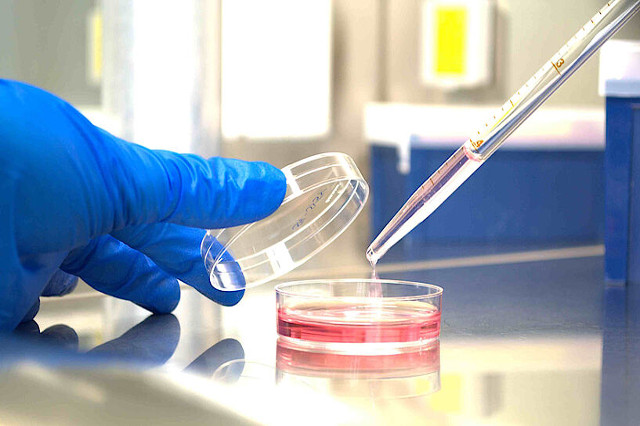
دیابت | آزمایش بهترین زمان مراجعه به آزمایشگاه برای تست قند

برای کنترل دقیق دیابت و پیشگیری از عوارض جدی آن، انتخاب بهترین زمان مراجعه به آزمایشگاه برای تست قند ضروری است. زمانبندی صحیح آزمایشهای قند خون، از ناشتا گرفته تا پس از غذا و تستهای بلندمدت مانند HbA1c، به پزشکان کمک میکند تا درکی جامع و دقیق از وضعیت متابولیسم قند خون فرد به دست آورند. این رویکرد نه تنها به تشخیص بهموقع پیشدیابت و دیابت یاری میرساند، بلکه در تنظیم و ارزیابی اثربخشی برنامههای درمانی نیز نقشی حیاتی ایفا میکند. بهترین زمان مراجعه به آزمایشگاه برای انجام تست FBS، صبح زود است، معمولاً بین ساعت ۷ تا ۹ صبح.
مدیریت قند خون، امروزه به یکی از ارکان اصلی حفظ سلامت تبدیل شده است، بهویژه با افزایش شیوع دیابت و پیشدیابت در جامعه. بسیاری از افراد ممکن است بدون آگاهی از نوسانات طبیعی قند خون یا تاثیر عوامل مختلف بر آن، اقدام به مراجعه به بهترین آزمایشگاه های مشهد کنند و نتیجهای غیردقیق دریافت نمایند. این عدم دقت میتواند منجر به تشخیصهای نادرست یا تاخیر در شروع درمان مناسب شود که خود عوارض جبرانناپذیری در پی خواهد داشت. از این رو، آگاهی از پروتکلهای دقیق برای هر نوع تست قند خون و رعایت آنها، گامی اساسی در مسیر سلامت است. جهت دریافت لیست بهترین آزمایشگاه های مشهد روی لینک رو به رو https://mashhadchikoja.ir/laboratory-mashhad/ کلیک کنید.
چرا زمانبندی دقیق مراجعه به آزمایشگاه برای تست قند ضروری است؟
دقت در زمانبندی مراجعه به آزمایشگاه برای انجام تستهای قند خون، یک ضرورت پزشکی حیاتی است که فراتر از یک توصیه ساده میرود. نوسانات سطح قند خون در بدن انسان، پدیدهای طبیعی است که تحت تاثیر عوامل متعددی مانند زمان صرف غذا، نوع فعالیت بدنی، استرس، و حتی چرخههای هورمونی قرار دارد. به عنوان مثال، پدیده “طلوع” (Dawn Phenomenon) که در آن قند خون ناشتا در ساعات اولیه صبح، به دلیل ترشح هورمونهای خاصی مانند کورتیزول و هورمون رشد، بهطور طبیعی افزایش مییابد، میتواند بر نتایج آزمایش قند خون ناشتا تاثیر بگذارد. بدون در نظر گرفتن این نوسانات، تفسیر نتایج ممکن است به گمراهی منجر شود و تشخیص دقیق را دشوار سازد.
رعایت زمانبندی صحیح، بهویژه در تستهایی مانند قند خون ناشتا یا ۲ ساعت بعد از غذا، امکان ارزیابی عملکرد واقعی بدن در مدیریت گلوکز را فراهم میکند. اگر فرد قبل از آزمایش ناشتا، آب میوه نوشیده باشد یا شام سنگینی خورده باشد، نتیجه قند خون ناشتای او نمیتواند منعکسکننده وضعیت پایه بدن باشد. به همین ترتیب، تست قند خون پس از غذا زمانی ارزشمند است که دقیقا ۲ ساعت پس از شروع غذا گرفته شود تا توانایی لوزالمعده در ترشح انسولین و کنترل قند پس از جذب مواد غذایی، به درستی سنجیده شود. هرگونه انحراف از این زمانبندی، میتواند تصویر نادرستی از وضعیت متابولیک فرد ارائه دهد.

دقت در تشخیص، یکی از مهمترین دلایل برای رعایت پروتکلهای زمانبندی است. یک نتیجه نادرست میتواند فردی را که در مرحله پیشدیابت قرار دارد، به اشتباه فردی با قند خون طبیعی نشان دهد و در نتیجه، فرصت طلایی برای پیشگیری از دیابت نوع ۲ از دست برود. از سوی دیگر، ممکن است فردی به اشتباه دیابتی تشخیص داده شود که این موضوع، پیامدهای روانی و درمانی خاص خود را دارد. همچنین، برای بیماران دیابتی که تحت درمان هستند، پایش منظم و دقیق قند خون با رعایت زمانبندی، به پزشک کمک میکند تا اثربخشی داروها و تغییرات سبک زندگی را ارزیابی کند و در صورت لزوم، برنامه درمانی را بهینه سازد. این دقت، در نهایت به بهبود کیفیت زندگی و کاهش عوارض بلندمدت دیابت کمک شایانی میکند.
راهنمای جامع انواع تستهای قند خون آزمایشگاهی و بهترین زمان مراجعه برای هر یک
درک انواع مختلف تستهای قند خون و زمانبندی صحیح برای انجام هر یک، سنگ بنای تشخیص و مدیریت اثربخش دیابت است. هر تست هدف مشخصی را دنبال میکند و نیازمند آمادگیهای ویژهای است تا نتایج به دست آمده، معتبر و قابل اعتماد باشند. نادیده گرفتن این پروتکلها، نه تنها به نتایج نادرست منجر میشود، بلکه میتواند مسیر تشخیص و درمان را با چالش مواجه سازد. در ادامه به بررسی جامع هر یک از تستها و بهترین زمان مراجعه برای آنها میپردازیم.
آزمایش قند خون ناشتا (Fasting Blood Sugar – FBS/FPG)
آزمایش قند خون ناشتا (FBS یا FPG) یکی از متداولترین و اساسیترین تستها برای غربالگری و تشخیص پیشدیابت و دیابت نوع ۲ است. این تست، میزان گلوکز موجود در خون را پس از یک دوره ناشتایی کامل اندازهگیری میکند. هدف اصلی این آزمایش، ارزیابی سطح پایه قند خون و توانایی بدن در کنترل گلوکز بدون دخالت غذای اخیر است. نتیجه این تست، تصویر واضحی از وضعیت متابولیک فرد در حالت استراحت غذایی ارائه میدهد و به پزشک کمک میکند تا وجود هرگونه اختلال در تنظیم قند خون را شناسایی کند.
بهترین زمان مراجعه به آزمایشگاه برای انجام تست FBS، صبح زود است، معمولاً بین ساعت ۷ تا ۹ صبح. دلیل این زمانبندی این است که ناشتایی لازم برای این تست، حداقل ۸ تا ۱۲ ساعت است. شروع ناشتایی از شب قبل و خونگیری در صبح، این اطمینان را میدهد که قند خون تحت تاثیر مصرف غذا در ساعات گذشته قرار نگرفته است. آمادگیهای کلیدی برای این آزمایش شامل موارد زیر است:
- ۸ تا ۱۲ ساعت ناشتایی کامل قبل از آزمایش. در این مدت، تنها نوشیدن آب ساده مجاز است. از مصرف هرگونه نوشیدنی شیرین، چای، قهوه، آدامس یا سیگار پرهیز کنید.
- شب قبل از آزمایش، یک شام سبک و بدون قند زیاد مصرف کنید. از پرخوری و مصرف غذاهای پرکربوهیدرات و شیرین خودداری کنید.
- با مشورت پزشک، از مصرف داروهای خاصی که میتوانند بر سطح قند خون تاثیر بگذارند، مانند کورتیکواستروئیدها، اجتناب کنید.
- پرهیز از فعالیت بدنی شدید، مصرف الکل و سیگار قبل از تست.
- استراحت کافی و دوری از استرس نیز میتواند به نتایج دقیقتر کمک کند.
رعایت دقیق این نکات، از اهمیت بالایی برخوردار است تا نتیجه آزمایش FBS، حداکثر اعتبار تشخیصی را داشته باشد و از تشخیصهای نادرست جلوگیری شود.
آزمایش قند خون ۲ ساعت بعد غذا (2-Hour Postprandial Glucose – 2hPP/PPBS)
آزمایش قند خون ۲ ساعت بعد غذا، که با نامهای 2hPP یا PPBS نیز شناخته میشود، ابزاری ارزشمند برای بررسی توانایی بدن در مدیریت و کنترل سطح قند خون پس از صرف یک وعده غذایی است. این تست نشان میدهد که بدن شما چگونه گلوکز حاصل از غذا را پردازش میکند و لوزالمعده تا چه حد میتواند انسولین کافی برای کاهش قند خون به سطح طبیعی را تولید و ترشح کند. به عبارت دیگر، این آزمایش به ارزیابی پاسخ انسولینی بدن به یک بار گلوکز کمک میکند و در تشخیص اختلالات در متابولیسم قند، بهویژه در افرادی که قند خون ناشتای طبیعی دارند اما همچنان مشکوک به پیشدیابت یا دیابت هستند، کاربرد دارد.
بهترین زمان مراجعه به آزمایشگاه برای انجام این تست، دقیقاً ۲ ساعت پس از اولین لقمه از یک وعده غذایی استاندارد است. این وعده غذایی اغلب صبحانه است، اما میتواند هر وعده اصلی دیگری باشد که فرد به طور معمول مصرف میکند. نکته حیاتی، ثبت دقیق زمان شروع غذا خوردن است؛ زیرا خونگیری باید دقیقاً ۲ ساعت پس از آن انجام شود. آمادگیهای کلیدی برای مراجعه به آزمایشگاه عبارتند از:
- قبل از انجام این آزمایش، نیازی به ناشتایی طولانی مدت نیست، اما باید از شب قبل از پرخوری یا مصرف غذاهای غیرمعمول خودداری کرد.
- در روز آزمایش، یک وعده غذایی متعادل و معمول (نه پرحجم و نه رژیمی خاص) را در منزل میل کنید. این وعده باید شامل کربوهیدراتهای معمولی باشد که به طور روزمره مصرف میکنید.
- بلافاصله پس از شروع اولین لقمه از غذا، زمان را دقیقاً یادداشت کنید.
- در فاصله ۲ ساعته پس از غذا، از مصرف هرگونه غذا یا نوشیدنی (به جز آب ساده) و انجام فعالیت بدنی شدید پرهیز کنید. فعالیت بدنی میتواند بر سطح قند خون تاثیر بگذارد و نتیجه را مخدوش کند.
- دقیقاً ۲ ساعت پس از شروع غذا، به آزمایشگاه مراجعه کنید تا خونگیری انجام شود.
رعایت دقیق این زمانبندی و پروتکلها، اطمینان از صحت نتایج را فراهم میآورد و به پزشک کمک میکند تا تصمیمگیریهای درمانی مناسبی اتخاذ کند.
تست تحمل گلوکز خوراکی (Oral Glucose Tolerance Test – OGTT)
تست تحمل گلوکز خوراکی (OGTT) یک آزمایش تشخیصی جامع است که برای تشخیص دیابت بارداری، پیشدیابت، و گاهی دیابت نوع ۲، بهویژه زمانی که نتایج تستهای دیگر مبهم هستند، به کار میرود. این تست نشان میدهد که بدن شما در یک بازه زمانی مشخص چگونه به مقدار معینی از گلوکز واکنش نشان میدهد و آیا میتواند قند خون را پس از مصرف حجم زیادی از گلوکز، به درستی تنظیم کند. OGTT به دلیل ارائه یک تصویر دینامیک از پاسخ بدن به قند، در موارد خاص بسیار کاربردی است و میتواند اختلالات جزئی در متابولیسم گلوکز را که ممکن است با تستهای دیگر نادیده گرفته شوند، آشکار کند.
بهترین زمان مراجعه به آزمایشگاه برای انجام تست OGTT، صبح زود است. این تست نیازمند شروع در حالت ناشتا و طی کردن مراحل نمونهگیری در فواصل زمانی مشخص است. فرآیند این تست کمی طولانیتر از سایر آزمایشات قند خون است و معمولاً ۲ تا ۳ ساعت به طول میانجامد. آمادگیهای کلیدی برای مراجعه به آزمایشگاه شامل:
- ۸ تا ۱۲ ساعت ناشتایی کامل شب قبل از آزمایش (مانند تست FBS). در این مدت فقط آب ساده مجاز است.
- قبل از شروع تست، نمونهای از خون در حالت ناشتا (قند خون پایه) گرفته میشود.
- پس از نمونهگیری پایه، فرد باید یک محلول استاندارد گلوکز (معمولاً حاوی ۷۵ گرم گلوکز برای بزرگسالان غیرباردار و ۱۰۰ گرم برای دیابت بارداری) را در مدت زمان مشخصی (معمولاً ۵ دقیقه) بنوشد.
- نمونهگیریهای بعدی در فواصل زمانی مشخص (معمولاً ۱ و ۲ ساعت پس از مصرف محلول) انجام میشود. برای دیابت بارداری ممکن است نمونهگیری در فواصل ۱، ۲ و ۳ ساعت صورت گیرد.
- در طول انجام تست و در فاصله بین نمونهگیریها، فرد باید در آزمایشگاه بماند و از هرگونه حرکت و فعالیت زیاد، خوردن یا نوشیدن (به جز آب ساده و در صورت نیاز با مشورت آزمایشگاه) پرهیز کند.
- پرهیز از مصرف الکل و سیگار قبل و در حین آزمایش نیز ضروری است.
رعایت دقیق این مراحل و زمانبندی، برای اعتبار نتایج OGTT بسیار مهم است و به تشخیصهای صحیح و به موقع کمک میکند. این تست بهویژه در تشخیص دیابت بارداری، نقش حیاتی دارد تا سلامت مادر و جنین حفظ شود.
آزمایش هموگلوبین گلیکوزیله (Glycated Hemoglobin – HbA1c)
آزمایش هموگلوبین گلیکوزیله، که به اختصار HbA1c نامیده میشود، یکی از مهمترین و پرکاربردترین تستها در تشخیص، غربالگری و پایش دیابت است. این تست برخلاف سایر آزمایشات قند خون که سطح قند را در یک لحظه خاص اندازهگیری میکنند، میانگین سطح قند خون فرد را طی ۲ تا ۳ ماه گذشته ارائه میدهد. این ویژگی خاص، HbA1c را به ابزاری قدرتمند برای ارزیابی بلندمدت کنترل قند خون تبدیل کرده است. هموگلوبین گلیکوزیله نشاندهنده میزان قندی است که به هموگلوبین (پروتئین حملکننده اکسیژن در گلبولهای قرمز) چسبیده است. از آنجایی که عمر گلبولهای قرمز حدود سه ماه است، این تست یک دید کلی از وضعیت قند خون در این بازه زمانی میدهد.
یکی از مزایای بزرگ آزمایش HbA1c، عدم نیاز به ناشتایی یا آمادگی غذایی خاص است. این بدان معناست که فرد میتواند در هر زمان از روز و بدون نیاز به رعایت رژیم غذایی خاصی قبل از مراجعه به آزمایشگاه، این تست را انجام دهد. این راحتی، HbA1c را به یک گزینه مناسب برای بسیاری از افراد تبدیل کرده است. با این حال، برخی آمادگیهای کلی و نکات مهم وجود دارد که میتواند بر دقت نتایج تاثیر بگذارد:
- عدم نیاز به ناشتایی:شما میتوانید قبل از انجام تست HbA1c به طور معمول غذا بخورید و نیازی به رعایت ساعات ناشتایی نیست.
- داروها:نیازی به قطع داروهای خاص قبل از آزمایش نیست، مگر اینکه پزشک شما توصیه دیگری داشته باشد. با این حال، همیشه بهتر است فهرست داروهای مصرفی خود را به آزمایشگاه یا پزشک اطلاع دهید.
- شرایط پزشکی خاص:در صورتی که به بیماریهایی مانند کمخونی شدید، تالاسمی یا سایر اختلالات هموگلوبین مبتلا هستید، حتماً آزمایشگاه و پزشک را در جریان قرار دهید. این شرایط میتوانند بر نتایج HbA1c تاثیر بگذارند و منجر به تفسیر نادرست شوند.
- بارداری:در دوران بارداری، تفسیر HbA1c ممکن است کمی متفاوت باشد، لذا پزشک شما باید از وضعیت بارداری مطلع باشد.
به دلیل پایداری و عدم تاثیرپذیری از نوسانات لحظهای قند خون، HbA1c یک معیار قابل اعتماد برای ارزیابی طولانیمدت مدیریت دیابت و خطر عوارض آن محسوب میشود. این تست همچنین در غربالگری و تشخیص دیابت و پیشدیابت، بهویژه در افرادی که ممکن است به دلیل ناشتایی نادرست یا سایر عوامل، نتایج تستهای قند خون لحظهایشان مخدوش شود، نقش مهمی دارد.
آزمایش قند خون تصادفی (Random Blood Sugar – RBS)
آزمایش قند خون تصادفی (RBS) به معنای اندازهگیری سطح گلوکز خون در هر زمان از روز و بدون نیاز به هیچگونه آمادگی خاص یا رعایت ناشتایی است. هدف اصلی این تست، بررسی سریع قند خون در شرایطی است که نیاز به ارزیابی فوری وضعیت قند خون وجود دارد، مثلاً زمانی که فرد علائم نگرانکنندهای مانند تشنگی شدید، پرادراری، خستگی مفرط یا کاهش وزن بیدلیل را تجربه میکند. RBS معمولاً در شرایط اورژانسی یا به عنوان یک تست اولیه غربالگری مورد استفاده قرار میگیرد تا مشخص شود آیا سطح قند خون فرد به طور غیرطبیعی بالاست یا خیر.
بهترین زمان مراجعه به آزمایشگاه برای تست RBS، هر زمان است که علائم حاد یا نیاز به بررسی فوری وجود داشته باشد. این تست نیازی به آمادگی قبلی ندارد، بنابراین میتوان بلافاصله و بدون هیچ محدودیتی برای خونگیری اقدام کرد. با این حال، لازم به ذکر است که نتایج RBS به تنهایی معمولاً برای تشخیص قطعی دیابت کافی نیست و در صورت بالا بودن غیرطبیعی قند خون، نیاز به تایید با آزمایشهای دقیقتر مانند FBS، HbA1c یا OGTT است. آمادگیهای کلیدی برای این تست شامل:
- عدم نیاز به ناشتایی یا آمادگی غذایی خاص.
- نیازی به قطع داروهای معمول نیست، مگر اینکه پزشک دستور دیگری داده باشد.
- در صورت وجود علائم نگرانکننده، هرچه سریعتر برای انجام تست اقدام کنید.
RBS یک ابزار غربالگری سریع است که میتواند در تشخیص موارد اضطراری و نیاز به مداخلات پزشکی فوری بسیار کارآمد باشد، اما برای تشخیص قطعی و مدیریت بلندمدت دیابت، باید با سایر تستهای آزمایشگاهی تکمیل شود.
تفسیر نتایج آزمایش قند خون در آزمایشگاه

درک و تفسیر نتایج آزمایش قند خون، کلیدی برای مدیریت سلامت و تشخیص به موقع دیابت است. اعداد گزارش شده در برگه آزمایش، بسته به نوع تست (FBS، 2hPP، HbA1c یا OGTT) و واحد اندازهگیری (mg/dL یا mmol/L)، معانی متفاوتی دارند. این نتایج به سه دسته اصلی تقسیم میشوند: طبیعی، پیشدیابت (یا در معرض خطر) و دیابت. مشاوره با پزشک برای تفسیر دقیق و تشخیص نهایی اهمیت بسیار زیادی دارد، چرا که عوامل فردی متعددی میتوانند بر این اعداد تاثیر بگذارند.
برایقند خون ناشتا (FBS)، مقادیر زیر ۱۰۰ میلیگرم در دسیلیتر (mg/dL) یا کمتر از ۵.۶ میلیمول در لیتر (mmol/L) طبیعی در نظر گرفته میشود. اگر این مقدار بین ۱۰۰ تا ۱۲۵ mg/dL (۵.۶ تا ۶.۹ mmol/L) باشد، فرد در مرحله پیشدیابت قرار دارد و در معرض خطر بالایی برای ابتلا به دیابت نوع ۲ است. قند خون ناشتای ۱۲۶ mg/dL (۷ mmol/L) یا بیشتر، در دو آزمایش جداگانه، معمولاً نشاندهنده دیابت است.
در موردقند خون ۲ ساعت بعد غذا (2hPP)، سطوح کمتر از ۱۴۰ mg/dL (۷.۸ mmol/L) طبیعی است. مقادیر بین ۱۴۰ تا ۱۹۹ mg/dL (۷.۸ تا ۱۱.۰ mmol/L) بیانگر اختلال تحمل گلوکز و مرحله پیشدیابت است. اگر قند خون ۲ ساعت بعد غذا ۲۰۰ mg/dL (۱۱.۱ mmol/L) یا بیشتر باشد، به تشخیص دیابت کمک میکند.
برایآزمایش هموگلوبین گلیکوزیله (HbA1c)، مقادیر کمتر از ۵.۷ درصد طبیعی محسوب میشود. محدوده ۵.۷ تا ۶.۴ درصد نشاندهنده پیشدیابت است و HbA1c برابر یا بیشتر از ۶.۵ درصد، در دو آزمایش جداگانه، معمولاً به تشخیص دیابت منجر میشود. HbA1c یک میانگین سه ماهه است و به همین دلیل برای ارزیابی بلندمدت کنترل قند بسیار قابل اعتماد است.
تفسیر نتایج آزمایش قند خون نیازمند توجه به عوامل فردی و مشاوره تخصصی پزشک است. اعداد مرزی یا نتایج غیرمنتظره باید همواره توسط متخصص بررسی شوند تا تشخیص دقیق و به موقع صورت گیرد.
تست تحمل گلوکز خوراکی (OGTT)در ۲ ساعت: مقادیر کمتر از ۱۴۰ mg/dL (۷.۸ mmol/L) طبیعی است. بین ۱۴۰ تا ۱۹۹ mg/dL (۷.۸ تا ۱۱.۰ mmol/L) نشاندهنده اختلال تحمل گلوکز و در معرض خطر پیشدیابت است. اگر قند خون ۲۰۰ mg/dL (۱۱.۱ mmol/L) یا بیشتر باشد، به تشخیص دیابت کمک میکند.قند خون تصادفی (RBS): برای این تست، هیچ محدوده نرمال قطعی وجود ندارد، اما اگر قند خون ۲۰۰ mg/dL یا بیشتر، همراه با علائم کلاسیک دیابت (مانند تشنگی زیاد، پرادراری و کاهش وزن بیدلیل) باشد، به تشخیص دیابت اشاره دارد و نیاز به تایید با تستهای دیگر دارد. در نهایت، همیشه با پزشک خود در مورد نتایج صحبت کنید تا با توجه به سابقه پزشکی، داروها و سایر عوامل مرتبط، بهترین مسیر درمانی برای شما تعیین شود.
چه کسانی و با چه فواصل زمانی باید به آزمایشگاه مراجعه کنند؟
توصیههای مربوط به زمان و فواصل مراجعه به آزمایشگاه برای تست قند خون، بسته به وضعیت سلامتی فرد، عوامل خطر و سابقه خانوادگی دیابت، متفاوت است. آگاهی از این دستورالعملها به افراد کمک میکند تا نقش فعالتری در پیشگیری و مدیریت سلامت خود ایفا کنند. این رویکرد، در نهایت به تشخیص زودهنگام و کاهش عوارض جدی دیابت کمک میکند.
- افراد بدون سابقه دیابت و با سلامت عمومی:
- سنین بالای ۴۵ سال:توصیه میشود از سن ۴۵ سالگی به بعد، هر سه سال یک بار برای غربالگری دیابت، آزمایش قند خون ناشتا یا HbA1c انجام دهند.
- افراد با وزن زیاد یا چاقی:حتی در سنین پایینتر از ۴۵ سال، اگر فرد اضافه وزن یا چاقی دارد، باید غربالگری دیابت را آغاز کند و فواصل تکرار آزمایشها ممکن است کوتاهتر باشد (مثلاً هر ۱ تا ۲ سال).
- افراد با عوامل خطر بالا:
- کسانی که سابقه خانوادگی دیابت (پدر، مادر، خواهر یا برادر دیابتی) دارند، باید زودتر و با فواصل منظمتر مورد غربالگری قرار گیرند.
- افراد مبتلا به فشار خون بالا (۱۴۰/۹۰ میلیمتر جیوه یا بیشتر).
- افراد با کلسترول غیرطبیعی (HDL کمتر از ۳۵ mg/dL یا تریگلیسرید بالاتر از ۲۵۰ mg/dL).
- زنان با سابقه دیابت بارداری یا سندرم تخمدان پلیکیستیک (PCOS).
- افرادی که سابقه بیماریهای قلبی-عروقی دارند.
- این افراد ممکن است نیاز به انجام آزمایشهای سالانه یا حتی ۶ ماه یک بار داشته باشند، بسته به نظر پزشک.
- بیماران دیابتی (نوع ۱ و ۲):
- دیابت نوع ۱:این بیماران معمولاً نیاز به پایش روزانه و مکرر قند خون در خانه دارند و آزمایش HbA1c را هر ۳ تا ۶ ماه یک بار در آزمایشگاه انجام میدهند.
- دیابت نوع ۲:بسته به نوع درمان (رژیم غذایی، داروهای خوراکی یا انسولین) و کنترل قند خون، فواصل آزمایشات آزمایشگاهی متفاوت است. بسیاری از این بیماران نیز HbA1c را هر ۳ تا ۶ ماه یک بار و FBS یا 2hPP را با فواصل منظمتر (مثلاً هر چند ماه یک بار یا به صورت هدفمند) انجام میدهند. پزشک معالج، بهترین زمانبندی را بر اساس وضعیت بیمار تعیین میکند.
- زنان باردار:
- همه زنان باردار بین هفتههای ۲۴ تا ۲۸ بارداری، باید برای غربالگری دیابت بارداری با تست OGTT مورد بررسی قرار گیرند.
- اگر عوامل خطر بالاتری مانند سابقه دیابت بارداری قبلی یا چاقی وجود دارد، ممکن است غربالگری زودتر و در سه ماهه اول بارداری انجام شود.
مراجعه منظم به آزمایشگاه و پیگیری نتایج با پزشک، به ویژه از طریق پلتفرمهای اطلاعاتی مانند مشهد چی کجا که میتواند در یافتن خدمات آزمایشگاهی معتبر کمککننده باشد، گام مهمی در حفظ سلامت و پیشگیری از عوارض جدی دیابت است. همواره توصیه میشود برای تعیین دقیق فواصل زمانی آزمایشها و نوع تستهای مورد نیاز، با پزشک متخصص مشورت شود.
عوامل موثر بر نتیجه آزمایش قند خون در آزمایشگاه
دقت نتایج آزمایش قند خون، تنها به زمانبندی صحیح مراجعه به آزمایشگاه وابسته نیست، بلکه عوامل متعددی میتوانند بر این نتایج تاثیر بگذارند. آگاهی از این عوامل به شما کمک میکند تا با آمادگی کاملتر برای آزمایش اقدام کنید و از نتایج دقیقتری بهرهمند شوید. نادیده گرفتن این موارد، میتواند به نتایج کاذب و در پی آن، تشخیص یا درمان نادرست منجر شود.
- داروها:برخی داروها به طور مستقیم یا غیرمستقیم میتوانند سطح قند خون را تغییر دهند.
- افزایش قند خون:کورتیکواستروئیدها (مانند پردنیزولون)، برخی دیورتیکها (مانند تیازیدها)، داروهای ضد روانپریشی (بهویژه نسل دوم)، برخی داروهای ضدبارداری خوراکی، بتا-بلاکرها و داروهای ضدافسردگی سه حلقهای میتوانند باعث افزایش قند خون شوند.
- کاهش قند خون:برخی داروهای فشار خون (مانند مهارکنندههای ACE)، داروهای کاهشدهنده کلسترول و برخی آنتیبیوتیکها میتوانند سطح قند خون را کاهش دهند. همیشه قبل از آزمایش، لیست داروهای مصرفی خود را به پزشک و آزمایشگاه اطلاع دهید و هرگز بدون مشورت پزشک، مصرف داروهای خود را قطع نکنید.
- بیماریهای حاد و استرس:هرگونه بیماری حاد مانند عفونت، سرماخوردگی شدید، آنفولانزا، تب، جراحی یا حتی دندانپزشکی میتواند باعث افزایش موقت قند خون شود. استرس روانی شدید نیز با ترشح هورمونهایی مانند کورتیزول و آدرنالین، قند خون را بالا میبرد. در صورت بیماری یا استرس شدید، بهتر است زمان آزمایش را به تعویق بیندازید یا این شرایط را به آزمایشگاه و پزشک اطلاع دهید.
- فعالیت بدنی شدید:ورزش کردن به طور کلی برای کنترل قند خون مفید است، اما فعالیت بدنی بسیار شدید یا غیرعادی درست قبل از آزمایش میتواند بر نتایج تاثیر بگذارد. مثلاً ورزش شدید میتواند در برخی افراد قند خون را کاهش دهد و در برخی دیگر، به دلیل ترشح هورمونهای استرس، آن را افزایش دهد. توصیه میشود ۲۴ تا ۴۸ ساعت قبل از آزمایش از فعالیتهای بدنی شدید خودداری کنید.
- رژیم غذایی غیرمعمول:تغییرات ناگهانی و شدید در رژیم غذایی، مانند مصرف مقدار زیادی کربوهیدرات یا رژیمهای غذایی بسیار کم کربوهیدرات، میتواند بر نتایج قند خون، بهویژه در تستهای FBS و 2hPP، تاثیر بگذارد. توصیه میشود چند روز قبل از آزمایش، رژیم غذایی معمول و متعادلی داشته باشید.
- عوامل فیزیولوژیک:در زنان، چرخه قاعدگی میتواند نوساناتی در سطح هورمونها ایجاد کند که گاهی بر قند خون تاثیر میگذارد. همچنین، کمآبی بدن میتواند منجر به افزایش کاذب قند خون شود؛ بنابراین، نوشیدن آب کافی (به خصوص قبل از تستهای غیرناشتا) توصیه میشود.
- الکل و سیگار:مصرف الکل و سیگار قبل از آزمایش میتواند بر نتایج تاثیر منفی بگذارد. الکل میتواند قند خون را در ابتدا بالا و سپس به شدت پایین بیاورد. سیگار نیز میتواند به طور موقت قند خون را افزایش دهد. از مصرف این مواد قبل از آزمایش خودداری کنید.
تفاوت تست قند خون خانگی و آزمایشگاهی
با پیشرفت تکنولوژی، دستگاههای تست قند خون خانگی (گلوکومتر) به ابزاری رایج و کاربردی برای پایش روزانه قند خون تبدیل شدهاند. این دستگاهها به افراد دیابتی این امکان را میدهند که به سرعت و سهولت، سطح قند خون خود را در منزل اندازهگیری کنند. با این حال، مهم است که تفاوتهای اساسی بین تستهای خانگی و آزمایشگاهی را درک کنیم و بدانیم که چرا مراجعه منظم به آزمایشگاه، حتی با وجود پایش خانگی، همچنان یک ضرورت است.
دقت و کالیبراسیون:یکی از مهمترین تفاوتها در دقت اندازهگیری است. دستگاههای آزمایشگاهی استاندارد، با کالیبراسیون دقیق و استفاده از روشهای پیشرفته، نتایج بسیار قابل اعتمادتری ارائه میدهند. گلوکومترهای خانگی، اگرچه برای پایش روزانه کافی هستند، اما ممکن است خطای اندازهگیری بیشتری نسبت به آزمایشگاه داشته باشند. عوامل محیطی، نگهداری نامناسب دستگاه یا نوارهای تست، و خطای انسانی در هنگام نمونهگیری، میتوانند بر دقت نتایج خانگی تاثیر بگذارند. نتایج آزمایشگاهی به عنوان “استاندارد طلایی” برای تشخیص و تصمیمگیریهای درمانی در نظر گرفته میشوند.
تستهای تشخیصی تخصصی:آزمایشگاهها امکان انجام تستهای پیچیدهتری را دارند که در منزل قابل انجام نیستند. تستهایی مانند HbA1c که میانگین قند خون سه ماه گذشته را نشان میدهد، یا تست تحمل گلوکز خوراکی (OGTT) که برای تشخیص دیابت بارداری یا پیشدیابت به کار میرود، نیازمند تجهیزات تخصصی و پروتکلهای دقیق آزمایشگاهی هستند. این تستها اطلاعات جامعتری از وضعیت متابولیک فرد ارائه میدهند که برای تشخیص دقیق و ارزیابی جامع دیابت حیاتی است.
تشخیص رسمی و صدور گواهی:نتایج حاصل از آزمایشگاههای معتبر، مبنای رسمی برای تشخیص دیابت، شروع درمان، تنظیم دوز داروها و صدور گواهیهای پزشکی است. پزشکان برای تصمیمگیریهای مهم درمانی و ارزیابی اثربخشی مداخلات، به این نتایج آزمایشگاهی تکیه میکنند. نتایج خانگی، هرچند مفید هستند، اما به تنهایی برای تشخیص قطعی یا تغییرات مهم در برنامه درمانی کافی نیستند.
نقش مکمل دستگاههای خانگی:دستگاههای گلوکومتر خانگی ابزاری عالی برای پایش روزانه، مدیریت خودکار قند خون، و تنظیم سریع رژیم غذایی یا دوز انسولین در شرایط خاص هستند. آنها به بیماران کمک میکنند تا درک بهتری از واکنش بدن خود به غذا، فعالیت و داروها داشته باشند. اما این ابزارها مکمل تستهای آزمایشگاهی هستند، نه جایگزین آنها. برای تشخیص اولیه، تایید تشخیص، و ارزیابی بلندمدت کنترل دیابت، مراجعه منظم به آزمایشگاه ضروری است.
سوالات متداول (FAQ)
آیا میتوانم شب قبل از آزمایش قند خون ناشتا، آب بنوشم؟
بله، نوشیدن آب ساده قبل از آزمایش قند خون ناشتا مجاز است و حتی توصیه میشود تا از کمآبی بدن جلوگیری شود. اما از مصرف هرگونه نوشیدنی حاوی قند، چای، قهوه، یا آبمیوه خودداری کنید.
آیا در صورت مصرف داروی خاصی باید قبل از مراجعه به آزمایشگاه آن را قطع کنم؟
خیر، هرگز بدون مشورت پزشک خود مصرف داروها را قطع نکنید. حتماً پزشک و آزمایشگاه را در جریان داروهای مصرفی خود قرار دهید تا در تفسیر نتایج لحاظ شود.
چرا برای تشخیص دیابت بارداری، تست OGTT توصیه میشود و چگونه انجام میشود؟
تست OGTT به دلیل بررسی دقیق پاسخ بدن به بار گلوکز، روشی استاندارد برای تشخیص دیابت بارداری است. این تست با مصرف محلول گلوکز و خونگیری در فواصل زمانی مشخص انجام میشود.
آیا نتایج آزمایش قند خون ناشتا و HbA1c میتوانند با هم متفاوت باشند، و دلیل آن چیست؟
بله، ممکن است متفاوت باشند. قند خون ناشتا وضعیت لحظهای را نشان میدهد، در حالی که HbA1c میانگین قند خون ۲ تا ۳ ماه گذشته است. تفاوتها میتوانند به دلیل نوسانات اخیر قند یا شرایط خاص پزشکی باشند.
بهترین ساعت برای آزمایش قند خون ناشتا کدام است و چرا باید صبح زود مراجعه کرد؟
بهترین ساعت معمولاً بین ۷ تا ۹ صبح است. صبح زود مراجعه کردن اطمینان میدهد که دوره ناشتایی ۸ تا ۱۲ ساعته به درستی رعایت شده و قند خون تحت تاثیر پدیده “طلوع” یا غذا قرار نگرفته است.
چرا باید در زمانهای مختلف قند خون را چک کرد؟
چک کردن قند خون در زمانهای مختلف (ناشتا، بعد غذا، قبل خواب) به پزشک کمک میکند تا الگوی نوسانات قند خون را شناسایی کرده و تاثیر غذا، داروها و فعالیتهای روزانه را بر سطح قند خون ارزیابی کند.
آیا تست قند خون در خانه به اندازه آزمایشگاه دقیق است؟
دستگاههای خانگی برای پایش روزانه مناسباند، اما دقت آنها معمولاً کمتر از دستگاههای آزمایشگاهی استاندارد است. برای تشخیص قطعی و تصمیمات درمانی مهم، نتایج آزمایشگاهی معتبرتر هستند.
شب قبل از آزمایش قند خون چه بخوریم؟
شب قبل از آزمایش قند خون (به خصوص برای تست ناشتا یا OGTT)، توصیه میشود شام سبک و متعادلی میل کنید و از پرخوری یا مصرف غذاهای شیرین و پرکربوهیدرات پرهیز نمایید.
آب خوردن قبل از آزمایش قند ناشتا مجاز است؟
بله، آب خوردن قبل از آزمایش قند ناشتا مجاز و حتی توصیه میشود تا از کم آبی بدن جلوگیری شود و نمونهگیری راحتتر انجام شود.
نتیجهگیری
در نهایت، آگاهی ازبهترین زمان مراجعه به آزمایشگاه برای تست قندو رعایت دقیق آمادگیهای لازم، از جمله ناشتایی صحیح برای تستهای خاص و اطلاعرسانی درباره داروهای مصرفی، ارکان اصلی برای به دست آوردن نتایج دقیق و قابل اعتماد هستند. این دقت نه تنها در تشخیص زودهنگام پیشدیابت و دیابت نقشی حیاتی دارد، بلکه در مدیریت اثربخش بیماری و پیشگیری از عوارض بلندمدت آن نیز بسیار تعیینکننده است. ترکیب پایش منظم قند خون با تستهای آزمایشگاهی تخصصی، به بیماران و پزشکان این امکان را میدهد که تصویری جامع از وضعیت سلامت متابولیک داشته باشند.
با توجه به اهمیت روزافزون کنترل قند خون، توصیه میشود که تمامی افراد، بهویژه کسانی که در گروههای پرخطر قرار دارند یا سابقه خانوادگی دیابت دارند، با مشورت پزشک خود، برنامهای منظم برای غربالگری و پایش قند خون داشته باشند. این مسیر، در حفظ سلامتی و بهبود کیفیت زندگی، گامی اساسی و هوشمندانه محسوب میشود. همواره به یاد داشته باشید که برای دسترسی به اطلاعات معتبر سلامت و خدمات آزمایشگاهی در منطقه، میتوانید به پلتفرمهای اطلاعاتی معتبر مانندمشهد چی کجامراجعه کنید و مشاورههای لازم را دریافت نمایید.
آیا شما به دنبال کسب اطلاعات بیشتر در مورد "بهترین زمان مراجعه به آزمایشگاه برای تست قند" هستید؟ با کلیک بر روی کسب و کار ایرانی, پزشکی، آیا به دنبال موضوعات مشابهی هستید؟ برای کشف محتواهای بیشتر، از منوی جستجو استفاده کنید. همچنین، ممکن است در این دسته بندی، سریال ها، فیلم ها، کتاب ها و مقالات مفیدی نیز برای شما قرار داشته باشند. بنابراین، همین حالا برای کشف دنیای جذاب و گسترده ی محتواهای مرتبط با "بهترین زمان مراجعه به آزمایشگاه برای تست قند"، کلیک کنید.



